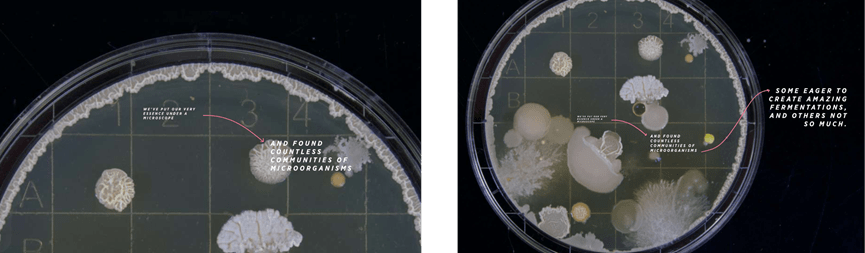
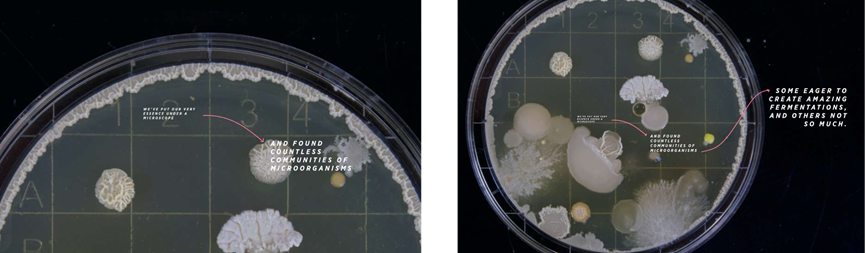

Το Fermentation σχετίζεται με τις μεθόδους επεξεργασίας των ώριμων κερασιών, και είναι η διαδικασία διάσπασης των υδρογονανθράκων και σακχάρων του cherry μέσω μικροοργανισμών: βακτηρίων, mold και yeast.

Στόχος της διαδικασίας του processing, είναι η αποφλοίωση του κόκκου από το cherry και η υγρασία του κόκκου να φτάσει από το 50%, στο 10-12%.

Το processing αποτελείται από 2 βασικά μέρη : Το Fermentation και το Drying.

Ένα παράδειγμα του wet processing, είναι το ακόλουθο:


Η μεταφορά του καρπού, γίνεται με τη βοήθεια του νερού, μέσω καναλιών σε δεξαμενές ζύμωσης.


Ο καρπός με το mucilage μένει για διάστημα 15-17 ώρες, σε θερμοκρασίες τοπικού περιβάλλοντος. Μετά το τέλος της ζύμωσης, μέσω πολλαπλών καναλιών, μεταφέρεται ο καρπός στα patios ή στα κρεβάτια (beds), για το στέγνωμα.

Το drying μπορεί να ολοκληρωθεί με μηχανικά μέσα, για μέγιστο έλεγχο της υγρασίας.

Με αυτήν την υγρασία μπορεί να φτάσει στα roastery για να καβουρδιστεί ο καφές.

Οι κλασικές μέθοδοι processing είναι: Natural, Washed και Pulped Natural / Honey.


Κατά τη διαδικασία του Natural Processing, τα ώριμα φρούτα στεγνώνουν μαζί με τον φλοιό και το mucilage στον ήλιο σε κρεβάτια (beds) ή patios.
Τα χαρακτηριστικά των καφέδων που έχουν δεχτεί Natural Processing, είναι τα berries, οι φράουλες, τα κόκκινα φρούτα, η κρεμώδης αίσθηση και η χαμηλή οξύτητα.

Κατά τη διαδικασία του Washed Processing, γίνεται απομάκρυνση φλοιού και μεταφορά των κόκκων σε δεξαμενές με τη χρήση νερού όπου μένουν για 15-17 ώρες ανάλογα με την θερμοκρασία. Κατόπιν, ακολουθεί το ξέπλυμά τους και το στέγνωμα σε κρεβάτια (beds) ή patios.
Οι καφέδες που έχουν δεχτεί Washed Processing, διακρίνονται από floral χαρακτηριστικά, citrusy και τροπικά φρούτα, έχουν υψηλότερη οξύτητα, malic acidity, juicy σώμα, και μας δίνουν συνήθως ένα «καθαρό» φλιτζάνι με μακρύ τελείωμα.



Κατά τη διαδικασία του Pulped Natural Processing, γίνεται απομάκρυνση του φλοιού και στέγνωμα με mucilage σε κρεβάτια (beds) ή patios.
Οι καφέδες που έχουν δεχτεί Pulped Natural Processing, έχουν γλυκά και κρεμώδη γευστικά χαρακτηριστικά, και μας δίνουν μέτρια οξύτητα και ισορροπημένο φλιτζάνι.


Την τελευταία 15ετία βλέπουμε εξέλιξη των παραδοσιακών μεθόδων επεξεργασίας, με σκοπό την ανάδειξη της πολυπλοκότητας, τα έντονα προφίλ, και την διαφορετικότητα.
Η εξέλιξη των honey εντοπίζεται κυρίως στην Costa Rica από τα τέλη του 2000 και μετά, διαφοροποίησε κατά πολύ τους καφέδες «παίζοντας» με το ποσοστό αφαίρεσης mucilage. Την εποχή που διανύουμε, εντοπίζονται οι εξής κατηγορίες:
- White Honey
- Yellow Honey
- Gold Honey
- Red Honey
- Black Honey
Η εξέλιξη των naturals έγινε με σκοπό την απόδοση πιο έντονων αρωμάτων και των γεύσεων κόκκινων φρούτων, όπως επίσης και την επίτευξη ενός πιο καθαρού aftertaste.
Την τελευταία 15ετία, εφαρμόζονται νέες μέθοδοι πιο sophisticated, με στόχο την ενδυνάμωση (intense) των γευστικών χαρακτηριστικών του καφέ.
H εξέλιξη περιλαμβάνει (αλλά δεν περιορίζεται σε) τις παρακάτω τεχνικές πριν από το τελικό στέγνωμα.
- Anaerobic fermentation

- Carbonic Maceration

- Supernatural


Η εξέλιξη των washed γίνεται με την βοήθεια εισαγωγής μικροοργανισμών – πέραν των φυσικών μικροοργανισμών της περιοχής.
Lactic: Η αφαίρεση του οξυγόνου κατά την διάρκεια αυτού του σταδίου ενισχύει τη μεγαλύτερη συμπύκνωση γαλακτικού οξέος ως αποτέλεσμα του mucilage carbohydrate fermentation, το οποίο εν συνεχεία συνεισφέρει στο γευστικό αποτέλεσμα ( έντονη γλυκύτητα – chocolatey & buttery υφή – velvety body).
Acetic: Είναι μία μορφή επεξεργασίας η οποία δεν περιλαμβάνει στάδιο pre-fermentation. Παρ ’όλα αυτά καθώς ο καρπός μπορεί να αλληλεπιδράσει με το οξυγόνο μετά την αποφλοίωση. Xαρακτηρίζεται ως μία αερόβια μορφή fermentation (medium bodied coffee – citrus like acidity).

H εξέλιξη θα συνεχίζεται, βρίσκοντας είτε ένθερμους υποστηρικτές είτε μετριοπαθείς, ενώ Όλο και περισσότερα “funky” processing methods έρχονται στο προσκήνιο.
Τα Alternative – Funky fermentations είναι τα εξής:
- Additive fermentation
- Inoculated (with a specific yeast or bacteria strain)
Μία ακόμα διαφορετική προσέγγιση, είναι αυτή του Bio – innovation. Πρόκειται για ορισμό που δόθηκε από τον στενό μας συνεργάτη στη La Palma & El Tucan, με σκοπό να γίνεται εκμετάλλευση των μικροοργανισμών του περιβάλλοντος της φάρμας.
Στόχος, μετά την ανάλυση, είναι οι κοινότητες μικροοργανισμών που δημιουργούν καλά αποτελέσματα, κρατιούνται, αποδίδουν και χρησιμοποιούνται για τα καθημερινά fermentations. Με αυτήν την προσέγγιση, “κρατάμε” τα χαρακτηριστικά του terroir, τη βιοποικιλότητα, χρησιμοποιούμε ό,τι μας δίνει η φύση και κρατάμε τα χαρακτηριστικά του οικοσυστήματος.
Η θέση μου: Προτιμώ ένα fermentation που δεν επηρεάζει το οικοσύστημα με κανέναν τρόπο, διότι είναι το αποτέλεσμα του σεβασμού και της μάθησης από τις συνθήκες του οικοσυστήματος, στο οποίο αυτό οι μικροοργανισμοί έχουν προσαρμοστεί. Σε όλη αυτή τη διαδικασία, η λέξη-κλειδί είναι η «Διαφάνεια».
Τα ακόλουθα χρόνια, είναι γεγονός ότι θα διαμορφωθεί ένας καινούργιος κόσμος καφέ μπροστά μας. Εξάλλου, η γεύση είναι υποκειμενική και έχει να κάνει με το τι αρέσει στον καθένα. Όμως, η διάχυση της πληροφορίας και η διαφάνεια είναι αυτά που θα βοηθήσουν τον καταναλωτή να κάνει την επιλογή του.
The evolution of processing and how it affects the taste characteristics of coffee
Fermentation is related to the processing methods of ripe cherries, and is the process of breaking down the hydrocarbons and sugars of the cherry through micro-organisms: bacteria, mold and yeast.

The goal of the processing process is to peel the grain from the cherry and to bring the moisture of the bean from 50% to 10-12%.

The processing consists of 2 main parts: Fermentation and Drying.

An example of wet processing, is the following:


The transport of the fruit is done with the help of water, through channels in fermentation tanks.


The fruit with the mucilage stays for 15-17 hours, at local ambient temperatures. After the end of fermentation, through multiple channels, the fruit is transferred to patios or beds, for drying.

Drying can be completed by mechanical means, for maximum moisture control.

With this moisture it can reach the roastery, to roast the coffee.

The classic processing methods are: Natural, Washed and Pulped Natural / Honey.


During the Natural Processing process, the ripe fruits are dried together with the peel and mucilage in the sun on beds or patios.
The characteristics of coffees that have received Natural Processing are berries, strawberries, red fruits, a creamy feel and low acidity.

During the Washed Processing process, the husk is removed and the grains are transferred to tanks using water where they stay for 15-17 hours depending on the temperature. Afterwards, they are rinsed and dried on beds or patios.
Coffees that have received Washed Processing are distinguished by floral characteristics, citrusy and tropical fruits, have higher acidity, malic acidity, juicy body, and usually give us a “clean” cup with a long finish.



During Pulped Natural Processing, the bark is removed and dried with mucilage on beds or patios.
The coffees that have received Pulped Natural Processing, have sweet and creamy taste characteristics, and give us moderate acidity and a balanced cup.


In the last 15 years, we have seen an evolution of traditional processing methods, with the aim of highlighting complexity, strong profiles, and diversity.
The evolution of honey can be found mainly in Costa Rica from the end of 2000 onwards, it greatly diversified the coffees by “playing” with the percentage of mucilage removal. At the time we are going through, the following categories are identified:
• White Honey
• Yellow Honey
• Gold Honey
• Red Honey
• Black Honey
The evolution of naturals was made with the aim of rendering more intense aromas and flavors of red fruits, as well as achieving a cleaner aftertaste.
In the last 15 years, new more sophisticated methods have been applied, with the aim of strengthening (intense) the taste characteristics of coffee.
Development includes (but is not limited to) the following techniques prior to final drying.
- Anaerobic fermentation

- Carbonic Maceration

- Supernatural


The evolution of the washed is done with the help of introducing microorganisms – in addition to the natural microorganisms of the area.
Lactic: The removal of oxygen during this stage enhances the greater concentration of lactic acid as a result of mucilage carbohydrate fermentation, which subsequently contributes to the taste effect (intense sweetness – chocolatey & buttery texture – velvety body).
Acetic: It is a form of treatment that does not include a pre-fermentation stage. Nevertheless, as the fruit can interact with oxygen after peeling. It is characterized as an aerobic form of fermentation (medium bodied coffee – citrus like acidity).

The evolution will continue, finding either ardent supporters or moderates, while more and more “funky” processing methods come to the fore.
The Alternative – Funky fermentations are the following:
• Additive fermentation
• Inoculated (with a specific yeast or bacteria strain)
Another different approach is that of Bio-innovation. This is a definition given by our close partner at La Palma & El Tucan, with the aim of exploiting the micro-organisms of the farm environment.
The goal, after analysis, is the communities of microorganisms that create good results, are kept, perform and are used for daily fermentations. With this approach, we “keep” the characteristics of the terroir, the biodiversity, use what nature gives us and keep the characteristics of the ecosystem.
My thesis: I prefer a fermentation that does not effect the ecosystem in any shame or form, because it is the result of respecting and learning from the conditions of the ecosystem, to which the microorganisms have adapted. In this whole process, the key word is ‘Transparency’.
In the following years, it is a fact that a new world of coffee will be formed in front of us. After all, taste is subjective and has to do with what everyone likes. But the diffusion of information and transparency are what will help the consumer to make his choice.
